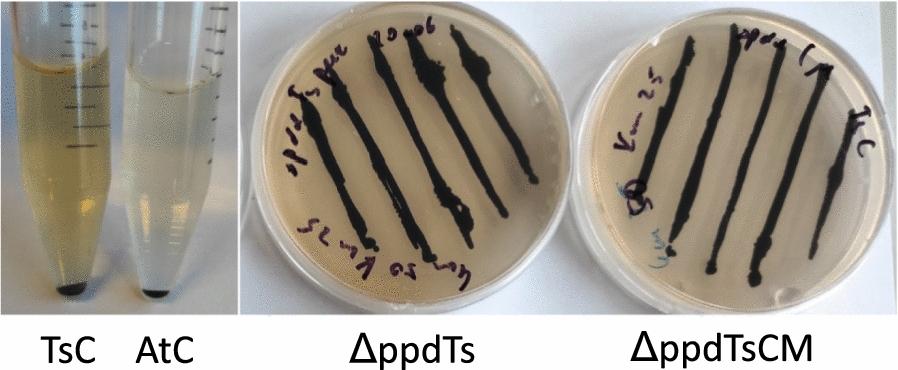

利用 Synechocystis sp. PCC 6803 进行代谢工程改造以提高苯丙素类物质的产量。
Metabolic engineering of Synechocystis sp. PCC 6803 for the improved production of phenylpropanoids.
机构信息
Microbial Chemistry, Department of Chemistry - Ångström, Uppsala University, Box 523, SE 751 20, Uppsala, Sweden.
出版信息
Microb Cell Fact. 2024 Feb 18;23(1):57. doi: 10.1186/s12934-024-02330-3.
BACKGROUND
Phenylpropanoids are a large group of plant secondary metabolites with various biological functions, derived from aromatic amino acids. Cyanobacteria are promising host organisms for sustainable production of plant phenylpropanoids. We have previously engineered Synechocystis sp. PCC 6803 to produce trans-cinnamic acid (tCA) and p-coumaric acid (pCou), the first intermediates of phenylpropanoid pathway, by overexpression of phenylalanine- and tyrosine ammonia lyases. In this study, we aimed to enhance the production of the target compounds tCA and pCou in Synechocystis.
RESULTS
We eliminated the 4-hydroxyphenylpyruvate dioxygenase (HPPD) activity, which is a competing pathway consuming tyrosine and, possibly, phenylalanine for tocopherol synthesis. Moreover, several genes of the terminal steps of the shikimate pathway were overexpressed alone or in operons, such as aromatic transaminases, feedback insensitive cyclohexadienyl dehydrogenase (TyrC) from Zymomonas mobilis and the chorismate mutase (CM) domain of the fused chorismate mutase/prephenate dehydratase enzyme from Escherichia coli. The obtained engineered strains demonstrated nearly 1.5 times enhanced tCA and pCou production when HPPD was knocked out compared to the parental production strains, accumulating 138 ± 3.5 mg L of tCA and 72.3 ± 10.3 mg L of pCou after seven days of photoautotrophic growth. However, there was no further improvement when any of the pathway genes were overexpressed. Finally, we used previously obtained AtPRM8 and TsPRM8 Synechocystis strains with deregulated shikimate pathway as a background for the overexpression of synthetic constructs with ppd knockout.
CONCLUSIONS
HPPD elimination enhances the tCA and pCou productivity to a similar extent. The use of PRM8 based strains as a background for overexpression of synthetic constructs, however, did not promote tCA and pCou titers, which indicates a tight regulation of the terminal steps of phenylalanine and tyrosine synthesis. This work contributes to establishing cyanobacteria as hosts for phenylpropanoid production.
背景
苯丙烷类是一大类具有多种生物功能的植物次生代谢物,来源于芳香族氨基酸。蓝藻是可持续生产植物苯丙烷类化合物的有前途的宿主生物。我们之前通过过表达苯丙氨酸和酪氨酸氨裂解酶,将 Synechocystis sp. PCC 6803 工程化为生产反式肉桂酸(tCA)和对香豆酸(pCou),这是苯丙烷途径的第一个中间体。在这项研究中,我们旨在提高 Synechocystis 中目标化合物 tCA 和 pCou 的产量。
结果
我们消除了 4-羟苯基丙酮酸双加氧酶(HPPD)的活性,该酶是一种竞争途径,会消耗酪氨酸,并且可能消耗苯丙氨酸用于生育酚合成。此外,单独或操纵子过表达了莽草酸途径的末端步骤的几个基因,例如芳香族转氨酶、来自运动发酵单胞菌的反馈不敏感环己二烯基脱氢酶(TyrC)和来自大肠杆菌的融合磷酸烯醇丙酮酸羧化酶/预苯酸脱水酶酶的分支酸变位酶(CM)结构域。与亲本生产菌株相比,当敲除 HPPD 时,获得的工程菌株的 tCA 和 pCou 产量分别提高了近 1.5 倍,在 7 天的光自养生长后,积累了 138±3.5mg/L 的 tCA 和 72.3±10.3mg/L 的 pCou。然而,当过表达任何途径基因时,都没有进一步的提高。最后,我们使用之前获得的具有不调控莽草酸途径的 AtPRM8 和 TsPRM8 Synechocystis 菌株作为背景,过表达带有 ppd 敲除的合成构建体。
结论
消除 HPPD 可在相似程度上提高 tCA 和 pCou 的生产力。然而,使用基于 PRM8 的菌株作为过表达合成构建体的背景,并没有促进 tCA 和 pCou 的产量,这表明苯丙氨酸和酪氨酸合成的末端步骤受到严格调控。这项工作有助于将蓝藻建立为苯丙烷类生产的宿主。